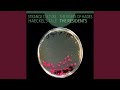

Strange Culture / The Rivers Of Hades / Haeckel's Tale - CD
Details
| Title | Strange Culture / The Rivers Of Hades / Haeckel's Tale |
| Artist | The Residents |
| Format | 2x CD |
| Labels | Klanggalerie |
| Country of issue | Europe |
| Date of publication | 21. January 2016 |
| First released | 2015 |
| Weight | 170 g |
| EAN | 4013438100927 |
| Product ID | 540631 |
| Discogs ID | 7797348 |
| Discogs reviews |
4.18
|
| Please note that the dimensions may vary slightly from piece to piece | |||||
Men's |
|||||
| T-SHIRTS | LONG SLEEVE T-SHIRTS | ||||
| SIZE | CHEST CIRCUMFERENCE (CM) | SIZE | CHEST CIRCUMFERENCE (CM) | ||
| XXL | 122 | XXL | 124.5 - 127 | ||
| XL | 117 | XL | 122 | ||
| L | 106.5 | L | 112 | ||
| M | 96.5 | M | 101.5 | ||
| S | 91.5 | S | 94 | ||
| HOODIES | SWEATSHIRTS WITH ZIP | ||||
| SIZE | CHEST CIRCUMFERENCE (CM) | SIZE | CHEST CIRCUMFERENCE (CM) | ||
| XXL | 127 | XXL | 119.5 - 124.5 | ||
| XL | 122 | XL | 112 - 117 | ||
| L | 112 | L | 104 - 109 | ||
| M | 101.5 | M | 96.5 - 101.5 | ||
| S | 91.5 | S | 89 - 94 | ||
Women's |
|||||
| T-SHIRTS | SKINNY FIT T-SHIRTS | ||||
| SIZE | CHEST CIRCUMFERENCE (CM) | SIZE | CHEST CIRCUMFERENCE (CM) | ||
| XL | 91.5 - 96.5 | L / XL | 91.5 - 96.5 | ||
| L | 86 - 91.5 | S / M | 81 - 86 | ||
| M | 81 - 86 | ONE SIZE | 81 approx. | ||
| S | 76 - 81 | ||||
| VESTS | SWEATSHIRTS WITH ZIP | ||||
| SIZE | CHEST CIRCUMFERENCE (CM) | SIZE | CHEST CIRCUMFERENCE (CM) | ||
| XL | 91.5 - 94 | L | 96.5 - 101.5 | ||
| L | 86 - 91.5 | M | 91.5 - 96.5 | ||
| M | 81 - 86 | S | 81 - 86 | ||
| S | 76 - 81 | ||||
We have everything!
Over
179 000
LP a
289 000
CD
on offer
Loyalty discount up to 5%
For registered customers
Have control!
The most advanced tracking
of availability and orders